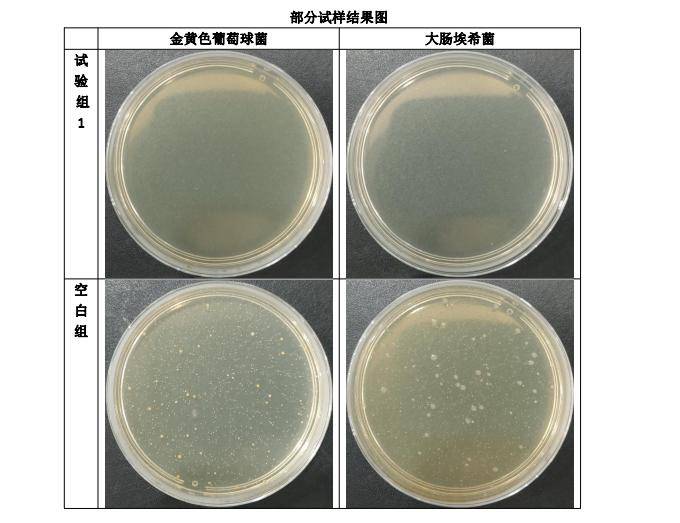
pu涂层抗菌涂层纸制品抗菌检测案例
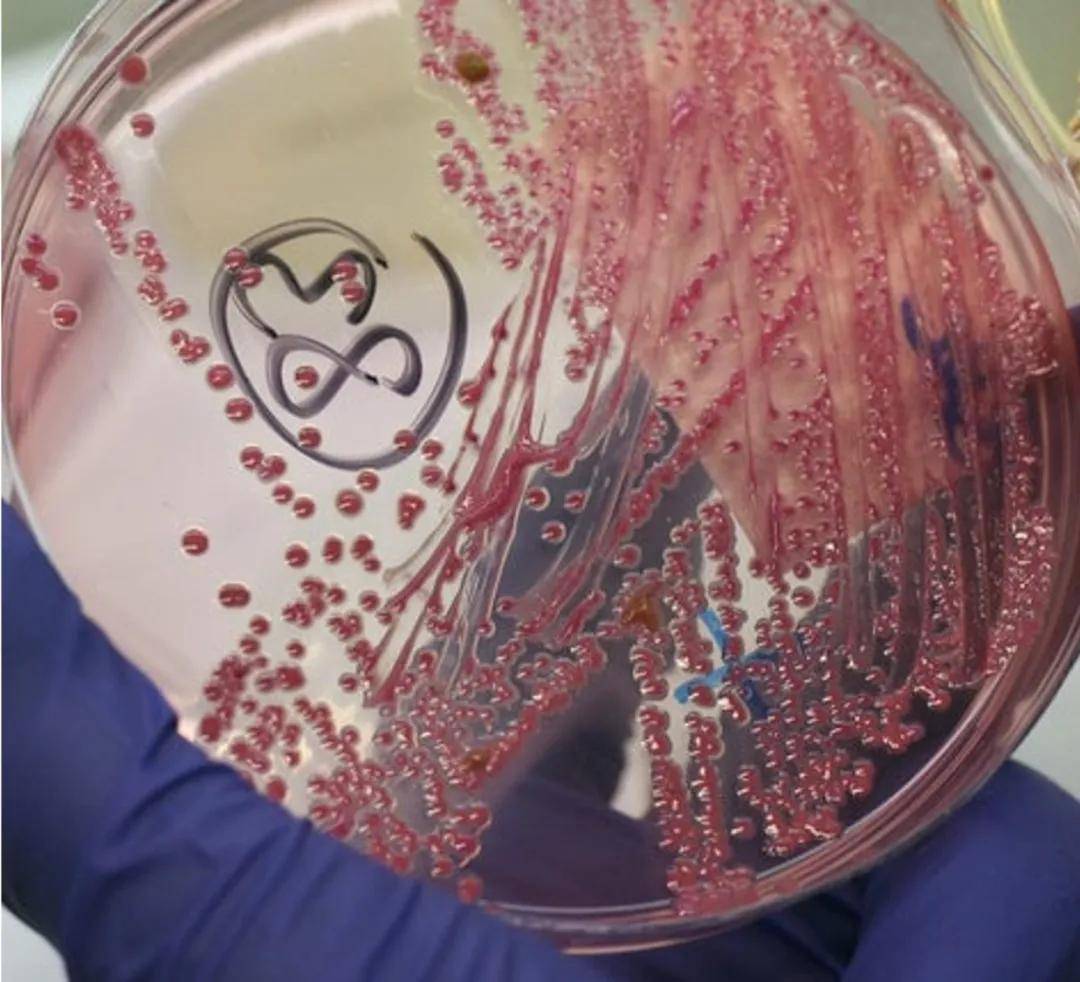
伦敦大学的研究人员设计了一种在环境照明下便能发挥作用的抗菌涂层

抗菌涂层

surfunbac抗菌涂层系列
图片尺寸347x279
抗菌涂层系列
图片尺寸1465x1466
抗菌涂层系列 - 百赛飞
图片尺寸700x220
pu涂层抗菌涂层纸制品抗菌检测案例
图片尺寸680x523
喷涂抗菌涂层-许晓霞摄.jpg
图片尺寸600x800
科学家开发新型疏水抗菌涂层让果蔬远离细菌交叉污染
图片尺寸500x269
纳米抗菌防护涂层
图片尺寸633x422
医用导管抗菌聚氨酯涂层进展
图片尺寸244x226
tzt0048sysmyk03超亲水长效抗菌纳米涂层手机玻璃专用型
图片尺寸750x361
有助减少传播感染,变形元素是抗菌涂层的关键!
图片尺寸1024x646
esco科学小贴士之isocide抗菌涂层技术
图片尺寸397x589
一种高透明性抗菌涂层,其制备方法及其应用
图片尺寸919x1091
纳米银涂层抗菌剂
图片尺寸1920x1440
伦敦大学的研究人员设计了一种在环境照明下便能发挥作用的抗菌涂层
图片尺寸1080x982
霉博士纳米银抗菌剂 油墨uv漆涂料涂层用 纳米级银离子抗菌剂
图片尺寸750x563
颐洁医用双组份抗菌自洁涂层
图片尺寸1000x861
抗菌与防护涂层材料
图片尺寸600x303
麦德美乐思直播预约高性能硬化涂层抗菌膜片及其应用介绍7月22日晚7点
图片尺寸882x626
"朱厂小课堂"——pvc墙布的抗菌工艺
图片尺寸1080x907
油漆抗菌剂涂料涂层抗菌剂
图片尺寸750x650